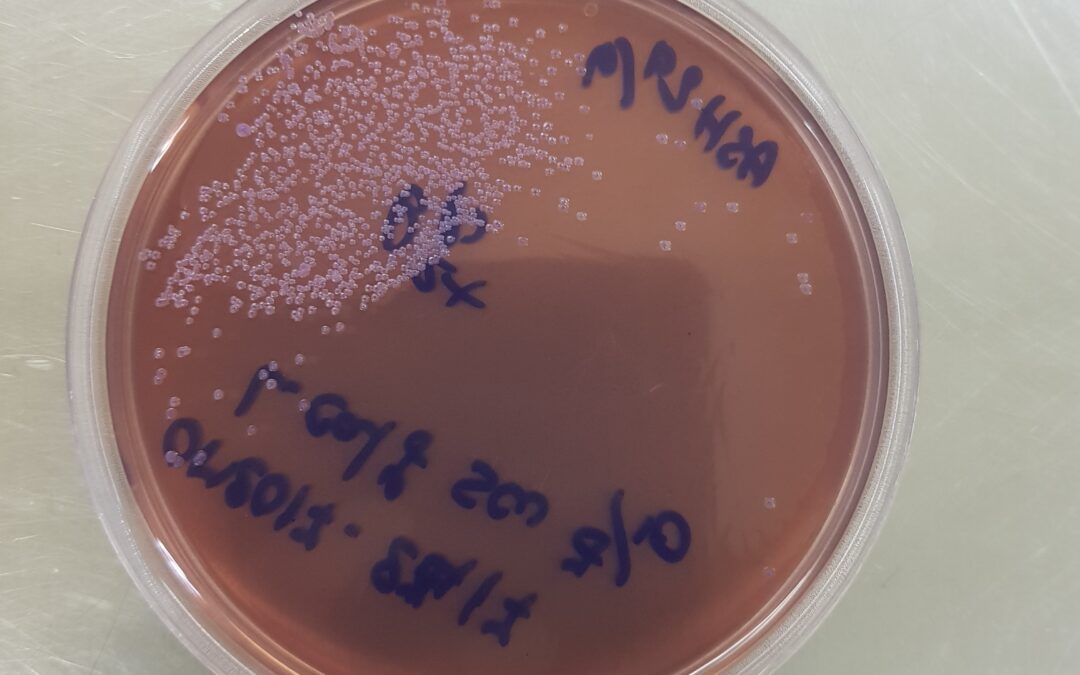
Allo studio un vaccino per le infezioni infantili

da Valentina Di Paola | Ott 31, 2025 | Daily newsletter, News, Salute
Roma – Sviluppare un vaccino unico in grado di proteggere i bambini da un insieme di infezioni potrebbe essere più semplice di quanto precedentemente ipotizzato. Questo incoraggiante risultato emerge da uno studio, pubblicato sulla rivista Nature Microbiology,...

da Gianmarco Pondrano d'Altavilla | Ott 31, 2025 | agrifood, Daily newsletter, In evidenza, News, Transizione ecologica
Roma – I ricercatori dell’Università di Cambridge hanno sviluppato un nuovo metodo per misurare l’impatto della nostra dieta sulla sopravvivenza delle specie animali in tutto il mondo. Il loro studio, pubblicato su Nature Food, rivela che tra 700 e 1.100...

da 30Science.com | Ott 31, 2025 | Daily newsletter, News, Ricerca Italiana, Salute
Roma – Un nuovo studio condotto dall’Università Roma Tre e dall’Istituto Nazionale di Geofisica e Vulcanologia (INGV) ha identificato la formazione o la riattivazione di una faglia all’interno della caldera dei Campi Flegrei, in corrispondenza...
da 30Science.com | Ott 31, 2025 | Humanities, News, Ricerca Italiana
Roma – La prova scientifica in ambito giuridico e dibattimentale può essere considerata tale solo dopo il vaglio di ricerche consolidate e una consensus conference internazionale. Lo ha affermato Francesco Introna, presidente della Società Italiana di Medicina...
da Valentina Arcovio | Ott 31, 2025 | News, Salute
Roma – Solo metà dei centri oncologici italiani dispone di percorsi nutrizionali strutturati e accessibili in modo uniforme, con forti differenze territoriali: sono soprattutto i centri del Nord a esserne dotati. E nella metà dei casi la valutazione...

da 30Science.com | Ott 31, 2025 | agrifood, antropologia, In evidenza, natura, News, Weekly newsletter
Roma – Quando pescano insieme ai delfini, i battiti cardiaci dei pescatori brasiliani si sincronizzano. Lo rivela uno studio dell’Università di Costanza, pubblicato sulla rivista Current Biology, che svela come la cooperazione tra esseri umani e animali...